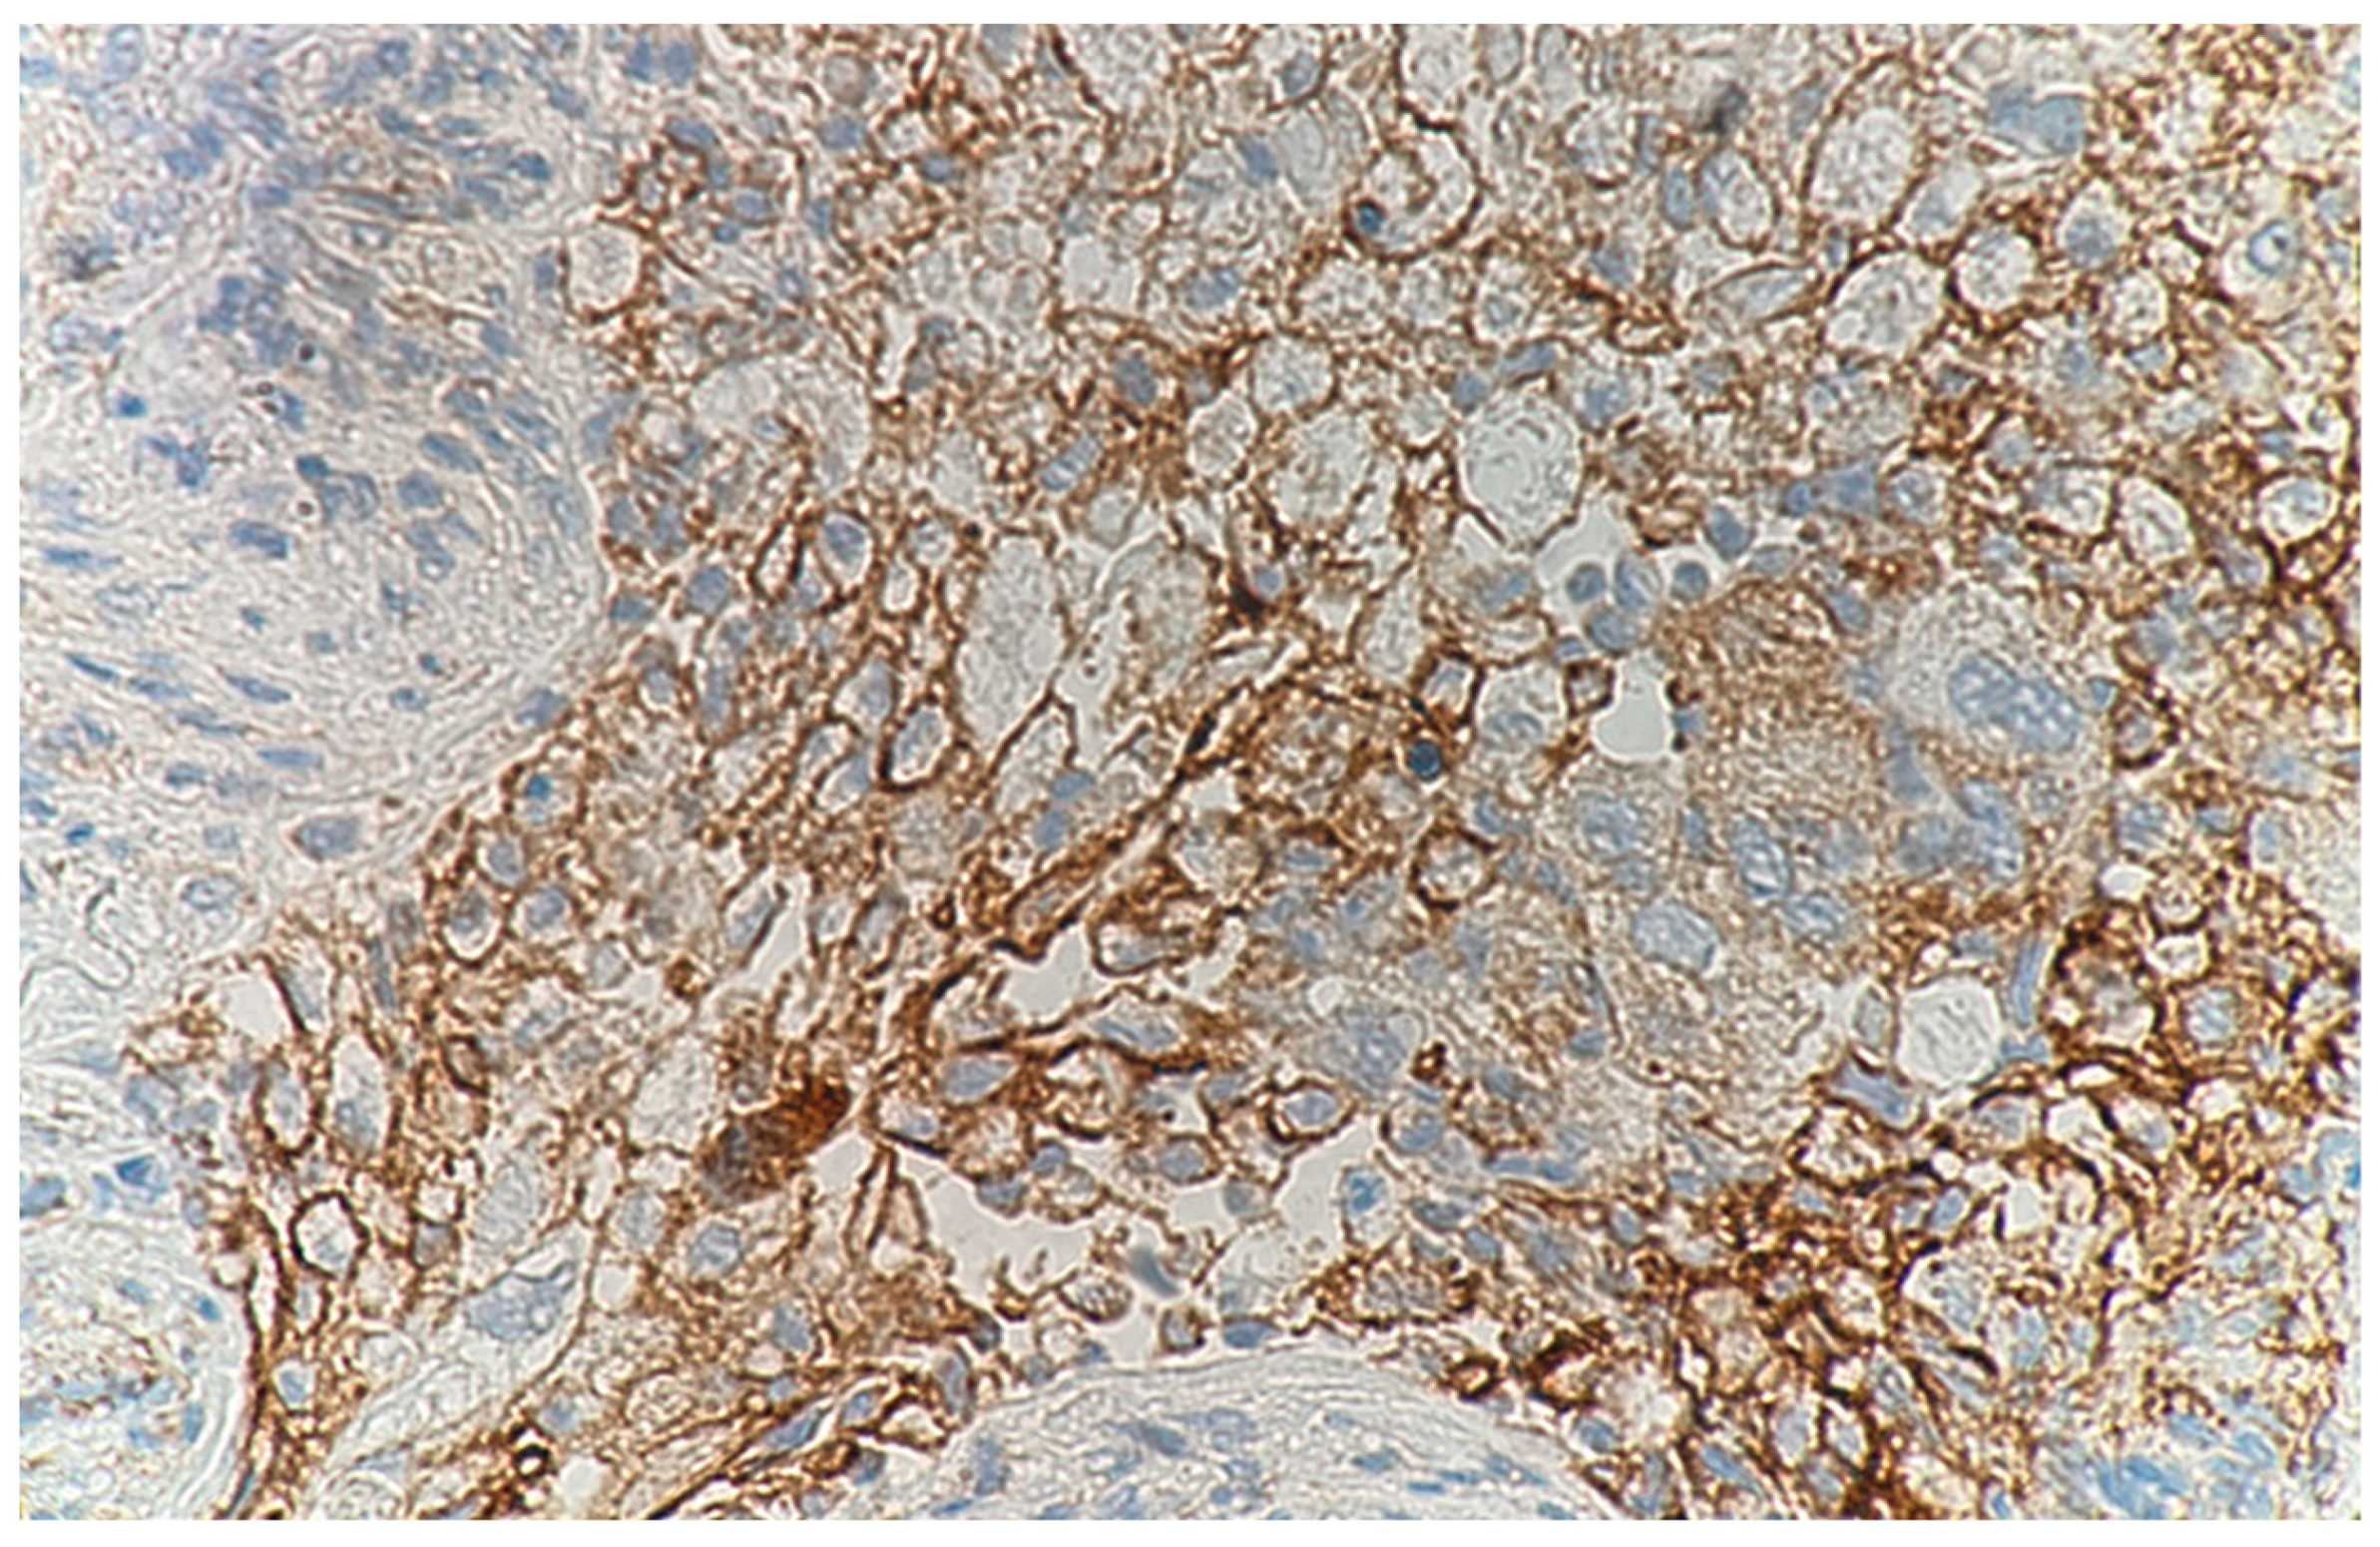
Medicina 59 00631 g003

Programmed Death-Ligand 1-Positive Squamous Cell Carcinoma Spontaneously Regressed after Percutaneous Needle Biopsy
Abstract
1. Introduction
2. Case Report
3. Discussion
4. Conclusions
Author Contributions
Funding
Institutional Review Board Statement
Informed Consent Statement
Data Availability Statement
Conflicts of Interest
References
- Everson, T.C. Spontaneous regression of cancer. Ann. N. Y. Acad. Sci. 1964, 114, 712–735. [Google Scholar] [CrossRef]
- Cole, W.H. Efforts to explain spontaneous regression of cancer. J. Surg. Oncol. 1981, 17, 201–209. [Google Scholar] [CrossRef] [PubMed]
- Iwanaga, T. Studies on cases of spontaneous regression of cancer in Japan in 2011, and of hepatic carcinoma, lung cancer and pulmonary metastases in the world between 2006 and 2011. Cancer Chemother. 2013, 40, 1475–1487. (In Japanese) [Google Scholar]
- Challis, G.B.; Stam, H.J. The spontaneous regression of cancer. A review of cases from 1900 to 1987. Acta Oncol. 1990, 29, 545–550. [Google Scholar] [CrossRef]
- Zhang, J.; Wang, H.; Li, C.; Qian, H. Chance to rein in a cancer--Spontaneous regression of lung carcinoma (1988–2018): A 30-year perspective. Int. J. Clin. Exp. Pathol. 2020, 13, 1190–1196. [Google Scholar]
- Sekine, A.; Oda, T.; Shintani, R.; Ikeda, S.; Baba, T.; Iwasawa, T.; Komatsu, S.; Hagiwara, E.; Ogura, T. Spontaneous regression following endobronchial ultrasound-guided transbronchial needle aspiration in lung cancer patients. Respir. Investig. 2021, 59, 691–694. [Google Scholar] [CrossRef] [PubMed]
- Kitai, H.; Sakakibara-Konishi, J.; Oizumi, S.; Hirohashi, Y.; Saito, W.; Kanda, A.; Sato, N.; Nishimura, M. Spontaneous regression of small cell lung cancer combined with cancer associated retinopathy. Lung Cancer 2015, 87, 73–76. [Google Scholar] [CrossRef] [PubMed]
- Yoon, H.-Y.; Park, H.S.; Cho, M.S.; Shim, S.S.; Kim, Y.; Lee, J.H. Spontaneous remission of advanced progressive poorly differentiated non-small cell lung cancer: A case report and review of literature. BMC Pulm. Med. 2019, 19, 210. [Google Scholar] [CrossRef]
- Papac, R.J. Spontaneous Regression of Cancer: Possible Mechanisms. In Vivo 1998, 12, 571–578. [Google Scholar]
- Kaiser, H.E.; Siegel, S.E.; Gröger, A.M.; Bodey, B. Spontaneous neoplastic regression: The significance of apoptosis. In Vivo 2000, 14, 773–788. [Google Scholar]
- Bodey, B. Spontaneous regression of neoplasms: New possibilities for immunotherapy. Expert Opin. Biol. Ther. 2002, 2, 459–476. [Google Scholar] [CrossRef]
- García-Hernández, M.D.L.L.; Uribe-Uribe, N.O.; Espinosa-González, R.; Kast, W.M.; Khader, S.A.; Rangel-Moreno, J. A Unique Cellular and Molecular Microenvironment Is Present in Tertiary Lymphoid Organs of Patients with Spontaneous Prostate Cancer Regression. Front. Immunol. 2017, 8, 563. [Google Scholar] [CrossRef] [PubMed]
- Fu, C.; Jiang, A. Dendritic Cells and CD8 T Cell Immunity in Tumor Microenvironment. Front. Immunol. 2018, 9, 3059. [Google Scholar] [CrossRef] [PubMed]
- Huntington, N.D.; Cursons, J.; Rautela, J. The cancer–natural killer cell immunity cycle. Nat. Rev. Cancer 2020, 20, 437–454. [Google Scholar] [CrossRef]
- Iwakami, S.-I.; Fujii, M.; Ishiwata, T.; Iwakami, N.; Hara, M.; Ihara, H.; Wada, R.; Tsutsumi, T.; Seyama, K.; Takahashi, K. Small-cell Lung Cancer Exhibiting Spontaneous Regression. Intern. Med. 2013, 52, 2249–2252. [Google Scholar] [CrossRef] [PubMed]
- Nogimori, C.; Yamamoto, H.; Nonaka, K.; Sazuka, M.; Hamaya, H.; Yamada, H. Spontaneous regression of lung cancer in an elderly patient: A case report. Jpn. J. Geriatr. 2017, 54, 555–559. [Google Scholar] [CrossRef] [PubMed]
- Ito, Y.; Kobayashi, H. A case of spontaneous regression of small cell lung cancer. J. Jpn. Assoc. Chest Surg. 2013, 27, 894–898. [Google Scholar] [CrossRef]
- Kawasaki, H.; Yoshida, J.; Yokose, T.; Suzuki, K.; Nagai, K.; Hojo, F.; Kodama, T.; Nishiwaki, Y. Primary Unknown Cancer in Pulmonary Hilar Lymph Node with Spontaneous Transient Regression: Report of a Case. Jpn. J. Clin. Oncol. 1998, 28, 405–409. [Google Scholar] [CrossRef]
- Blank, C.; Mackensen, A. Contribution of the PD-L1/PD-1 pathway to T-cell exhaustion: An update on implications for chronic infections and tumor evasion. Cancer Immunol. Immunother. 2007, 56, 739–745. [Google Scholar] [CrossRef]
- Belai, E.B.; de Oliveira, C.E.; Gasparoto, T.H.; Ramos, R.N.; Torres, S.A.; Garlet, G.P.; Cavassani, K.A.; Silva, J.S.; Campanelli, A.P. PD-1 blockage delays murine squamous cell carcinoma development. Carcinogenesis 2014, 35, 424–431. [Google Scholar] [CrossRef]
- Ricketts, T.D.; Prieto-Dominguez, N.; Gowda, P.S.; Ubil, E. Mechanisms of macrophage plasticity in the tumor environmSent: Manip-ulating activation state to improve outcomes. Front Immunol. 2021, 12, 642285. [Google Scholar] [CrossRef] [PubMed]
- Kaneda, M.M.; Messer, K.S.; Ralainirina, N.; Li, H.; Leem, C.J.; Gorjestani, S.; Woo, G.; Nguyen, A.V.; Figueiredo, C.C.; Foubert, P.; et al. PI3Kγ is a molecular switch that controls immune suppression. Nature 2016, 539, 437–442. [Google Scholar] [CrossRef]
- Burtness, B.; Harrington, K.J.; Greil, R.; Soulières, D.; Tahara, M.; de Castro, G., Jr.; Psyrri, A.; Basté, N.; Neupane, P.; Bratland, A.; et al. Pembrolizumab alone or with chemotherapy versus cetuximab with chemotherapy for recurrent or metastatic squamous cell carcinoma of the head and neck (KEYNOTE-048): A randomised, open-label, phase 3 study. Lancet 2019, 394, 1915–1928. [Google Scholar] [CrossRef]
- Yamaguchi, H.; Muto, S.; Inomata, S.; Watanabe, M.; Ozaki, Y.; Okabe, N.; Matsumura, Y.; Shio, Y.; Suzuki, H. A Case of Lung Squamous Cell Carcinoma That Regrew Four Months After Spontaneous Regression Following a Transbronchial Biopsy. Haigan 2022, 62, 103–106. [Google Scholar] [CrossRef]
- Jeong, J.H.; Choi, P.J.; Yi, J.H.; Jeong, S.S.; Lee, K.N. Lymph Node Metastasis after Spontaneous Regression of Non-Small Cell Lung Cancer. Korean J. Thorac. Cardiovasc. Surg. 2019, 52, 119–123. [Google Scholar] [CrossRef] [PubMed]

Disclaimer/Publisher’s Note: The statements, opinions and data contained in all publications are solely those of the individual author(s) and contributor(s) and not of MDPI and/or the editor(s). MDPI and/or the editor(s) disclaim responsibility for any injury to people or property resulting from any ideas, methods, instructions or products referred to in the content. |
© 2023 by the authors. Licensee MDPI, Basel, Switzerland. This article is an open access article distributed under the terms and conditions of the Creative Commons Attribution (CC BY) license (https://creativecommons.org/licenses/by/4.0/).
Share and Cite
Sasahara, M.; Takahashi, H.; Ohchi, T.; Nomura, N.; Kodama, K.; Ikeda, K.; Nishikiori, H.; Okamoto, K.; Chiba, H. Programmed Death-Ligand 1-Positive Squamous Cell Carcinoma Spontaneously Regressed after Percutaneous Needle Biopsy. Medicina 2023, 59, 631. https://doi.org/10.3390/medicina59030631
Sasahara M, Takahashi H, Ohchi T, Nomura N, Kodama K, Ikeda K, Nishikiori H, Okamoto K, Chiba H. Programmed Death-Ligand 1-Positive Squamous Cell Carcinoma Spontaneously Regressed after Percutaneous Needle Biopsy. Medicina. 2023; 59(3):631. https://doi.org/10.3390/medicina59030631
Chicago/Turabian StyleSasahara, Masayuki, Hiroki Takahashi, Takashi Ohchi, Naohiro Nomura, Kentaro Kodama, Kimiyuki Ikeda, Hirotaka Nishikiori, Kenzo Okamoto, and Hirofumi Chiba. 2023. "Programmed Death-Ligand 1-Positive Squamous Cell Carcinoma Spontaneously Regressed after Percutaneous Needle Biopsy" Medicina 59, no. 3: 631. https://doi.org/10.3390/medicina59030631
APA StyleSasahara, M., Takahashi, H., Ohchi, T., Nomura, N., Kodama, K., Ikeda, K., Nishikiori, H., Okamoto, K., & Chiba, H. (2023). Programmed Death-Ligand 1-Positive Squamous Cell Carcinoma Spontaneously Regressed after Percutaneous Needle Biopsy. Medicina, 59(3), 631. https://doi.org/10.3390/medicina59030631

